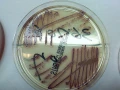
HML提供 水質菌落數檢測與大腸桿菌檢測

健康國際管理顧問有限公司
加入時間:2010-05-10資本額:200萬
瀏覽次數:248by:HML
全身健康檢查、DNA鑑定.胎兒早期性別鑑定
全身健康檢查、DNA鑑定.胎兒早期性別鑑定、愛滋病HIV.唐氏症、中西藥品類固醇、HPV.HBV.HCV.量.病理切片.動物檢驗
全身健康檢查、DNA鑑定.胎兒早期性別鑑定、.毒品.愛滋病HIV.唐氏症、中西藥品類固醇、HPV.HBV.HCV.量.病理切片.過敏原.動物檢驗.歡迎美容.生技、藥廠、學校.公家.醫院合作。網址:www.HML.tw (負責人:鍾政達)家族團體公司行號預約到府~打造專屬健康套組
相關產品
-
全身健康檢查、DNA鑑定.胎兒早期性別鑑定
全身健康檢查、DNA鑑定.胎兒早期性別鑑定、愛滋病HIV.唐
相關服務
-

~(西螺)HML健康醫事檢驗所~健康檢查
HML全身健康檢查費用2010/09/30 11:02
-
HML提供 水質菌落數檢測與大腸桿菌檢測
HML健康醫事檢驗所提供相關水質檢驗:每單位
-

提供最新 禿頭基因 & 抗老化基因檢測
HML健康醫事檢驗所提供~提供最新 禿頭基因 & 抗
-

專業過敏原實驗室~(微流體晶片)
優點: 1.民眾自費1800~
-

DNA-親子鑑定(台灣法律案+匿名)均可
1.健康醫事檢驗所(健保機構碼9439041147.
-

B.C型DNA.RNA肝炎愛滋病毒量檢測
健康醫事檢驗所(設備照片)提供:HCV.HBV亞型/基因型檢
-

健康檢查費用與檢查觀念(健康醫事檢驗所)
( 歡迎列印此頁面) 我們不以包山包海的檢驗項目,浪費醫療資
-

健康醫事檢驗所-提供"性病""愛滋病檢查
檢驗項目: 1.尿液查規檢查費用共50元(含尿道炎).2.
-
相關詢價
-
想詢問抽血檢驗過敏原有分哪幾種項目類別以及收費謝謝
來自:蔡OO 詢價
***0925@gmail.com
-
錠狀食品ORAC(親水-親油-TOTAL)與SOD LIKE
來自:淯OO份OO公O 詢價
***en0800034706@gmail.com
-
請問公司用血壓計租賃或買斷價錢
來自:杏OO司 詢價
***sai@sinphar.com.tw
https://034504053.web66.com.tw/web/NMD?postId=877278組合式過濾槽
組合式過濾桶,是由單槽式過濾桶,組合串連而成,適合錦鯉池過濾,生態水池,景觀水池過濾等整套內附有生化濾材,UVC殺菌燈,等適合約4噸大小的魚池使用!清洗時相當方便,只需將下方清潔口打開,由上方沖水清洗
關鍵字:
#健檢篩驗#全身健康檢查#DNA鑑定#胎兒早期性別鑑定#愛滋病HIV#唐氏症#中西藥品類固醇#HPV.HBV.HCV#病理切片#過敏原#動物檢驗

